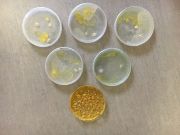
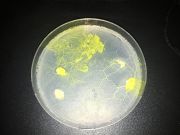
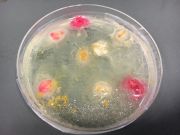
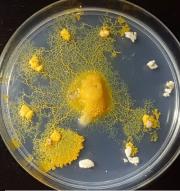
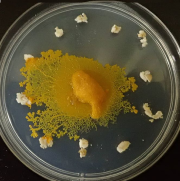
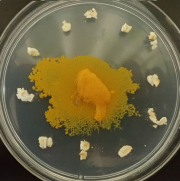
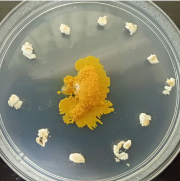
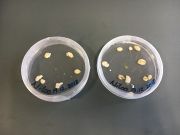
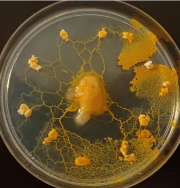

This special page shows all uploaded files.
| Date | Name | Thumbnail | Size | Description | Versions |
|---|---|---|---|---|---|
| 18:23, 20 March 2019 | Video6.mp4 (file) | 21.5 MB | File uploaded with MsUpload | 1 | |
| 18:05, 20 March 2019 | 1.mp4 (file) | 13.75 MB | File uploaded with MsUpload | 1 | |
| 17:25, 20 March 2019 | IMG 6878.JPG (file) |  |
2.05 MB | File uploaded with MsUpload | 2 |
| 17:24, 20 March 2019 | 18.JPG (file) |  |
1.88 MB | File uploaded with MsUpload | 1 |
| 17:23, 20 March 2019 | 35.JPG (file) |  |
1.69 MB | File uploaded with MsUpload | 1 |
| 17:21, 20 March 2019 | 46.JPG (file) |  |
2.03 MB | File uploaded with MsUpload | 2 |
| 17:20, 20 March 2019 | 43.JPG (file) |  |
2.19 MB | File uploaded with MsUpload | 1 |
| 17:20, 20 March 2019 | IMG 6944.JPG (file) |  |
1.47 MB | File uploaded with MsUpload | 1 |
| 17:19, 20 March 2019 | 32.JPG (file) |  |
1.63 MB | File uploaded with MsUpload | 1 |
| 17:06, 20 March 2019 | 30.JPG (file) | |
1.81 MB | File uploaded with MsUpload | 1 |
| 16:57, 20 March 2019 | IMG 6807.JPG (file) |  |
1.84 MB | File uploaded with MsUpload | 2 |
| 16:48, 20 March 2019 | IMG 6804.JPG (file) |  |
1.69 MB | File uploaded with MsUpload | 1 |
| 16:48, 20 March 2019 | IMG 6707.JPG (file) |  |
1.98 MB | File uploaded with MsUpload | 1 |
| 16:47, 20 March 2019 | IMG 6706.JPG (file) |  |
2.23 MB | File uploaded with MsUpload | 1 |
| 16:45, 20 March 2019 | 22.JPG (file) |  |
1.97 MB | File uploaded with MsUpload | 1 |
| 16:43, 20 March 2019 | 28.JPG (file) |  |
2.46 MB | File uploaded with MsUpload | 1 |
| 16:43, 20 March 2019 | 27.JPG (file) |  |
2.2 MB | File uploaded with MsUpload | 1 |
| 16:42, 20 March 2019 | 29.JPG (file) | |
2.9 MB | File uploaded with MsUpload | 1 |
| 15:03, 20 March 2019 | 600.jpeg (file) |  |
2.01 MB | File uploaded with MsUpload | 1 |
| 16:45, 6 January 2019 | IMG 6716.JPG (file) | |
1.88 MB | File uploaded with MsUpload | 1 |
| 16:45, 6 January 2019 | IMG 6717.JPG (file) |  |
1.82 MB | File uploaded with MsUpload | 1 |
| 16:40, 6 January 2019 | IMG 6750.JPG (file) |  |
1.92 MB | File uploaded with MsUpload | 1 |
| 16:40, 6 January 2019 | IMG 6749.JPG (file) |  |
1.72 MB | File uploaded with MsUpload | 1 |
| 16:34, 6 January 2019 | IMG 6760.JPG (file) |  |
1.96 MB | File uploaded with MsUpload | 1 |
| 16:34, 6 January 2019 | IMG 6751.JPG (file) |  |
2.02 MB | File uploaded with MsUpload | 1 |
| 16:29, 6 January 2019 | IMG 6671.JPG (file) |  |
2.25 MB | File uploaded with MsUpload | 2 |
| 16:24, 6 January 2019 | IMG 6665.JPG (file) |  |
1.47 MB | File uploaded with MsUpload | 1 |
| 16:24, 6 January 2019 | IMG 6661.JPG (file) |  |
1.94 MB | File uploaded with MsUpload | 1 |
| 16:01, 6 January 2019 | MIC (5).JPG (file) |  |
4.05 MB | File uploaded with MsUpload | 1 |
| 16:01, 6 January 2019 | MIC (4).JPG (file) |  |
4.33 MB | File uploaded with MsUpload | 1 |
| 16:01, 6 January 2019 | MIC (3).JPG (file) |  |
4.35 MB | File uploaded with MsUpload | 1 |
| 15:49, 6 January 2019 | IMG 6777.JPG (file) |  |
1.6 MB | File uploaded with MsUpload | 1 |
| 15:48, 6 January 2019 | IMG 6774.JPG (file) |  |
1.68 MB | File uploaded with MsUpload | 1 |
| 15:48, 6 January 2019 | IMG 6772.JPG (file) |  |
1.67 MB | File uploaded with MsUpload | 1 |
| 15:46, 6 January 2019 | IMG 6770.JPG (file) |  |
1.51 MB | File uploaded with MsUpload | 1 |
| 15:40, 6 January 2019 | IMG 6767.JPG (file) |  |
1.71 MB | File uploaded with MsUpload | 1 |
| 15:30, 6 January 2019 | IMG 6763.JPG (file) |  |
1.49 MB | File uploaded with MsUpload | 1 |
| 16:52, 2 January 2019 | Bio11 (50).PNG (file) |  |
802 KB | File uploaded with MsUpload | 1 |
| 16:52, 2 January 2019 | Bio1 (48).PNG (file) |  |
961 KB | File uploaded with MsUpload | 1 |
| 16:52, 2 January 2019 | Bio1 (47).PNG (file) |  |
926 KB | File uploaded with MsUpload | 1 |
| 16:52, 2 January 2019 | Bio11 (49).PNG (file) | |
938 KB | File uploaded with MsUpload | 1 |
| 16:52, 2 January 2019 | Bio1 (46).PNG (file) |  |
822 KB | File uploaded with MsUpload | 1 |
| 16:52, 2 January 2019 | Bio1 (45).PNG (file) | |
643 KB | File uploaded with MsUpload | 2 |
| 16:52, 2 January 2019 | Bio1 (44).PNG (file) | |
626 KB | File uploaded with MsUpload | 1 |
| 16:52, 2 January 2019 | Bio1 (43).PNG (file) |  |
719 KB | File uploaded with MsUpload | 2 |
| 16:52, 2 January 2019 | Bio1 (42).PNG (file) | |
726 KB | File uploaded with MsUpload | 1 |
| 16:51, 2 January 2019 | Bio1 (41).PNG (file) |  |
599 KB | File uploaded with MsUpload | 1 |
| 16:44, 2 January 2019 | Bio (162).JPG (file) | |
1.82 MB | File uploaded with MsUpload | 2 |
| 16:42, 2 January 2019 | Bio (158).JPG (file) |  |
1.82 MB | File uploaded with MsUpload | 2 |
| 01:12, 2 January 2019 | Bio1 (50).PNG (file) | |
802 KB | File uploaded with MsUpload | 1 |